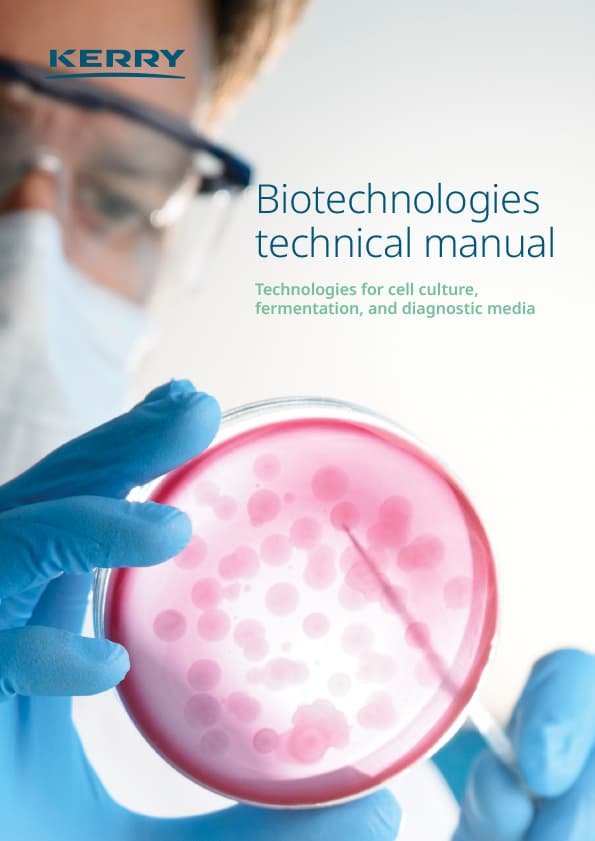
Catalogue image

At Kerry, we make it our business to exceed your expectations every day. We have strong recognition in the Pharma and Biotech sectors, with a history of scientific references totaling more than 500.
Kerry Group – Ireland’s Global Taste, Nutrition & Pharma Supplier
Kerry deliver the Industrys most extensive Lactose product line in the Industry, including anhydrous, spray dried, monohydrate, andinhalation grades of lactose. The Sheffield™ Brand N.F. Anhydrous Direct Tableting (DT) lactose has been recognized since its originalpatent as the standard of comparison for anhydrous direct compression lactose excipients in the industry.